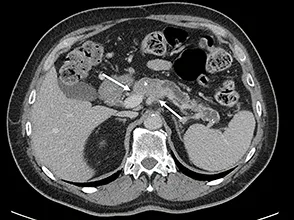
Figure 3 : AP borderline artériel. Envahissement veineux (VMS) < 180° et artériel (AMS) < 180°

Liens d’intérêt
L’auteur déclare n’avoir aucun lien d’intérêt avec sa communication
Mots-clés
Adénocarcinome du pancréas ; Résécabilité et résécabilité secondaire ; Traitement néoadjuvant et d’induction
Résumé
Bien que la chirurgie soit le seul traitement potentiellement curatif, une survie prolongée ne peut se concevoir sans chimiothérapie (CT) systémique associé (CT d’induction, néoadjuvante et/ou adjuvante). Les objectifs des équipes médico-chirurgicales doivent donc être la réalisation d’un bilan pré-thérapeutique complet permettant de classer la tumeur selon le stade de resécabilité anatomique, tout en prenant en considération les situations dites « limites » ou « borderline ». Des données importantes semblent montrer un intérêt au recours à CT néoadjuvante pour l’adénocarcinome résécable, mais la supériorité de cette approche n’est pas encore complètement démontrée. La prise en charge oncologique dépend strictement des critères anatomiques, pour la décision des traitements dits d’induction. La CT est la référence, en première intention pour les formes non résécables d’emblée (borderline et localement avancé non résécable), mais la place de la radio-chimiothérapie complémentaire ou de clôture n’est pas clairement définie. La sélection des patients potentiellement candidats à une exérèse chirurgicale après traitement d’induction, correspond à des bilans de réévaluation complet lors de chaque changement de stratégie et répond à des critères bien précis. L’objectif d’une exérèse R0, doit rester la priorité et l’évaluation de la résécabilité secondaire doit être faite dans des centres habitués à la prise en charge de ces patients.
Introduction
L’adénocarcinome canalaire pancréatique (AP) reste une maladie dévastatrice et s’est hissé au rang de troisième cause de mortalité liée au cancer. En 2021, on estime que le cancer du pancréas touchera 60 430 patients aux États-Unis et sera responsable d’environ 48 220 décès (1). Parmi toutes les modalités de traitement, la chirurgie constitue la seule option curative ; cependant, seuls 15 à 20 % des patients sont candidats à une résection. Même chez ces patients, dont la maladie semble localisée, les taux de récidive à distance sont élevés, ce qui se traduit par une survie globale (SG) à 5 ans de 10 % avec la chirurgie seule (2). Ces taux élevés d’échec à distance suggèrent que l’AP est une maladie systémique au moment du diagnostic, même dans le cadre d’une maladie localisée sur le plan anatomique.
Des recherches considérables ont été consacrées à l’amélioration de la survie des patients atteints d’AP et, grâce à une meilleure compréhension de la biologie tumorale et à de nouvelles combinaisons de thérapies systémiques, la SG à 5 ans, tous stades confondus, a finalement atteint la barre des 10 % (https://seer.cancer.gov/statfacts/html/pancreas. html. Accessed 23 May 20.). Bien que ces progrès soient encourageants, il reste encore une grande marge d’amélioration. Pour optimiser la prise en charge des patients présentant un AP localisé, plusieurs points sont essentiels à prendre en considération :
- Appréhender les critères précis de résécabilité, en intégrant les données cliniques et biologiques, sans se focaliser sur les seuls critères anatomiques et radiologiques.
- Adapter la stratégie thérapeutique en accord avec ces critères de résécabilité en intégrant la place respective de la chimiothérapie (CT) néoadjuvante, d’induction, de la radiochimiothérapie (RCT) et de la chirurgie d’exérèse.
- Connaître les options thérapeutiques en cas de cancer résécable et leurs résultats
- Connaître les options thérapeutiques en situation d’induction et les indications de résection chirurgicale
Classification anatomique
Historique et définition
Il est bien établi que le pronostic des patients opérés pour un AP dépend fortement du statut histopathologique, et en particulier des marges d’exérèse chirurgicale. En effet, l’exérèse complète en marges microscopiquement négatives (résection R0) est associée au meilleur pronostic postopératoire. À noter que la définition consensuellement admise pour une exérèse R0 est une distance entre la tumeur et la marge chirurgicale de 1 mm, depuis les travaux de Delpero et collaborateurs en 2014 (3). À l’inverse, les patients opérés avec exérèse chirurgicale dont les marges sont histologiquement positives (résection R1) présentent une durée de SG plus courte dans la plupart des séries (4-7). De plus, les patients présentant une maladie résiduelle macroscopique (R2) après la chirurgie ont un pronostic similaire à celui des patients opérés sans exérèse tumorale (laparotomie exploratrice) et qui sont traités dans un but palliatif.
Pour ces raisons, la probabilité d’obtenir une exérèse avec des marges chirurgicales saines R0 est une considération majeure pour déterminer si un patient est un candidat potentiel pour une pancréatectomie à visée carcinologique (8). Une évaluation précise de la résécabilité représente la composante la plus critique du bilan préthérapeutique.
Telle qu’elle a été décrite pour la première fois dans les années 1990 (9,10), la résécabilité « borderline » ou « marginale » était une désignation anatomique utilisée pour décrire les tumeurs qui semblaient envahir la veine mésentérique supérieure (VMS) et/ ou la veine porte (VP), l’artère hépatique, l’artère mésentérique supérieure (AMS) ou les organes adjacents sur l’imagerie en coupe, car la prise en charge chirurgicale était associée à des taux élevés de marges positives, de complications postopératoires, de récidive et de mortalité précoce.
La plupart des définitions de la résécabilité anatomique des AP évalue l’extension locorégionale et vasculaire mésentérique (8,11). Ces définitions reposent sur 5 observations cliniques :
- La résection complète de la tumeur primaire et des ganglions lymphatiques régionaux est obligatoire pour la survie à long terme ;
- Plus l’extension locorégionale et vasculaire (VMS-VP, AMS en particulier) est importante, plus le risque d’exérèse R1/ R2 augmente ;
- La réalisation d’une résection veineuse (VMS-VP) et/ou de l’artère hépatique, mais pas de l’AMS, lors de la pancréatectomie est associée à des résultats oncologiques acceptables ;
- Le « downstagin » des cancers localement avancés est possible après l’administration d’agents cytotoxiques conventionnels ;
- La CT et la RCT peuvent être utilisées pour sélectionner les patients dont la physiologie et la biologie tumorale sont favorables et qui peuvent bénéficier de gestes de pancréatectomies élargies.
Les deux définitions les plus souvent utilisées dans la littérature, toutes deux basées sur les données d’imagerie scanographique, sont celles proposées par l’équipe du MD Anderson Cancer Center (MDACC) (12) et celle adoptée lors d’une conférence de consensus américaine et modifiée ultérieurement par le National Comprehensive Cancer Network (8).
En synthèse, les critères anatomiques utilisés désignent un AP
- résécable en l’absence de preuve d’une atteinte significative de la veine porte ou veine mésentérique ou artérielle,
- à la limite de la résécabilité, ou « borderline » en présence de signe évocateur d’un envahissement veineux ou artériel mésentérique mineur à modéré,
- non résécable, en présence de signes d’occlusion veineuse porto-mésentérique non reconstructible ou d’atteinte artérielle significative.
En 2006, le National Comprehensive Cancer Network (NCCN) a donc adopté le terme « borderline resectable » pour décrire les cancers localisés considérés comme présentant un risque élevé de résection en marge positive et d’échec du traitement après chirurgie première, et pour lesquels l’administration d’un traitement néoadjuvant ou d’induction devait être proposé. Bien que cette approche nous paraisse logique en 2022, l’ISGPS (International Surgery Group of Pancreatic Surgery) recommandait encore la chirurgie première pour ces lésions borderline en 2014 (13). Et il aura fallu attendre les résultats de l’étude ESPAC-5F pour confirmer que la chirurgie première n’était pas à proposer dans cette situation d’AP avec envahissement vasculaire, même si techniquement extirpable (14).
La définition de la résécabilité de l’AP a été revue et affinée, avec en 2018, l’adoption d’une classification consensuelle internationale (14) (tableau 1, figures 1 à 4).
| | | Localement Avancé Non Resecable |
| | | Absence (présence de métastases ganglionnaires extrarégional) |
| Absence de contact artériel (TC, AMS, AHC) | Atteinte céphalique ou du crochet : - Contact tumoral de l’AHC sans extension au TC ou à la bifurcation artérielle hépatique autorisant une résection complète avec reconstruction
- Contact tumoral de l’AMS <180°
- Contact tumoral de variantes anatomiques artérielles
Atteinte corporéocaudale : - Contact tumoral du TC <180°
- Contact tumoral du TC >180° sans envahissement de l’aorte et avec respect de l’AGD.
| Atteinte céphalique ou du crochet : - Contact tumoral de l’AMS >180°
- Contact tumoral du TC >180° Atteinte corporéocaudale :
- Contact tumoral du TC ou de l’AMS > 180°
- Contact tumoral du TC avec envahissement de l’aorte
|
| Absence de contact veineux au niveau de la VMS ou de la VP,
OU contact veineux sans irrégularité du contour de la veine. | Contact tumoral de la VMS/VP >180°, Contact tumoral <180° irrégularité du contour de la veine mais respect distal et proximal autorisant une résection vasculaire oncologique Contact tumoral de la VCI | Atteinte céphalique ou du crochet : - Axe VMS/VP non accessible à une reconstruction chirurgicale en raison de l’envahissement tumoral, ou occlusion veineuse
- Envahissement veineux des principales veines jéjunales de drainage veineux mesenterique, contre indiquant une reconstruction
Atteinte corporéocaudale : - Axe VMS/VP non accessible à une reconstruction chirurgicale en raison de l’envahissement tumoral, ou occlusion veineuse
|
AGD : Artère gastroduodenale ; AHC : Artère hépatique commune ; AMS : Artère mésentérique supérieure ; TC : Tronc coeliaque ; VCI : Veine cave inférieure. (selon la classification NCCN 2019, ISAJI 2018)

Figure 1 : AP résécable. Absence de contact veineux. Tumeur peu hypodense en scanner ayant nécessité un complément de documentation pancréatique par IRM
La dichotomie est à présent plus claire, permettant même de distinguer les atteintes veineuses des atteintes artérielles.
Une atteinte « borderline veineux » correspond à l’envahissement isolé de l’axe mesentéricoportal (VMS/VP seule) et est définie par un contact tumoral de 180 degrés ou plus ou par un envahissement VMS/VP avec réduction de calibre ou occlusion bilatérale, et ne dépassant pas le bord inférieur du duodénum.
Une atteinte « borderline artérielle » correspond à un envahissement artériel avec ou sans envahissement veineux. Elle est définie par :
- un contact tumoral avec l’AMS et/ ou le tronc cœliaque inférieur à 180 degrés sans présenter de sténose ou de déformation ;
- un contact tumoral avec l’artère hépatique commune sans atteinte de l’artère hépatique propre et/ou du tronc cœliaque.
Qualité de l’examen scannographique (15)
Avant toute décision thérapeutique, il est nécessaire de réaliser un bilan morphologique de qualité. L’examen de référence est le scanner (TDM). Selon la NCCN, l’exploration en TDM d’un patient suspect de présenter un AP requiert une technique d’exploration optimisée incluant des acquisitions multiphasiques après injection de produit de contraste (8). L’examen tomodensitométrique doit être hélicoïdal, réalisé avec des coupes millimétriques ou inframillimétriques, réalisé après ingestion orale d’un verre d’eau et injection de produit de contraste iodé, mais aussi permettre des reconstructions multi-planaires. Les temps d’acquisition doivent être respectés : au temps pancréatique (entre 35 et 50 secondes après l’injection, le plus souvent à 45 secondes) centrées sur la glande pancréatique et au temps portal sur la région abdomino-pelvienne (15).
L’examen d’imagerie doit être réalisé dans un délai de 1 mois avant l’initiation du traitement, dans le cas contraire, il doit être renouvelé.

Figure 2 : AP isthmique, résécable d’emblée selon la définition du NCCN, présentant un contact veineux < 180°

Figure 3 : AP borderline artériel. Envahissement veineux (VMS) < 180° et artériel (AMS) < 180°
Récidive précoce et maladie systémique – prise en considération des situations borderline « biologique »
En pratique, l’utilisation exclusive de définitions anatomiques de la résécabilité a une valeur limitée en ce qui concerne l’estimation du pronostic chez les patients atteints de AP localisé, car chaque stade anatomiquement défini comprend en fait une population cliniquement hétérogène. En effet, plus de 50 % des patients atteints de cancers résécables ne seront pas opérés, et la durée de survie des patients inopérables atteints de cancers résécables est similaire à celle des patients atteints de maladies métastatiques (16).
De plus, bien que le taux de survie à 5 ans des patients ayant bénéficié d’une séquence de traitement complet (chirurgie + CT adjuvante) soit d’environ 30 %, le taux de récidive dans les 2 premières années est de plus de 50 % (17,18).
Ainsi, aucune définition de la résécabilité anatomique existant ne permet d’identifier de manière adéquate les patients dits « bons candidats » pour la chirurgie.
L’équipe du MD Anderson a proposé, déjà en 2008, 2 sous-ensembles supplémentaires de patients, dits « à risque » ou « borderline » : les patients avec une suspicion de maladie métastatique (borderline biologique, borderline B) et les patients avec un état clinique sous-optimal ou des comorbidités médicales importantes nécessitant une évaluation prolongée ou une optimisation (borderline Clinique, borderline C). L’inclusion de ces 2 derniers groupes dans la catégorie des patients à la limite de la résécabilité permet une stadification précise de tous les patients qui présentent un AP nouvellement diagnostiqué. Les critères MDACC ajoutent donc aux critères anatomiques (type A) décrits précédemment 2 ensembles supplémentaires de critères pour l’AP de type B et de type C à la limite de la résécabilité (19).
Ce point est majeur, en particulier à l’ère du néoadjuvant (20). La résécabilité doit être évaluée en tenant compte des risques d’extension locorégionale et à distance. En raison de la variabilité et de l’hétérogénéité des tumeurs, de petites tumeurs peuvent présenter des caractéristiques invasives et métastatiques précoces. Le modèle de dissémination précoce de la maladie métastatique suggérant un processus précoce avant même qu’un volume critique de la tumeur primitive ne soit atteint, a été proposé pour l’AP (21).
Il est ainsi nécessaire de proposer un bilan préthérapeutique très précis avec un taux de CA19-9, un scanner thoracique, abdominal et pelvien selon des recommandations précises préalablement mentionnées et une IRM hépatique et potentiellement, dans certaines situations, une exploration chirurgicale par cœlioscopie.

Figure 4 : AP localement avancé non résécable. Envahissement du TC > 180° et de l’AMS < 180°
CA 19-9 et marqueurs circulants
Ces hypothèses sont actuellement confirmées sur le plan clinique. L’étude de Groot et al. (17) a tenté de définir le meilleur seuil pour caractériser la récidive précoce. Le délai de survie sans récidive pour distinguer la récidive précoce de la récidive tardive était de 12 mois. Dans cette étude, les patients présentant une récidive précoce avaient des taux de survie à 1 et 2 ans après la récidive de 20 et 6 %, contre 45 et 22 % pour le groupe de récidive tardive (p < 0,001). Pour les patients présentant une récidive précoce, les médianes de survie sans maladie et de SG étaient respectivement de 6,5 et 13 mois. Ces résultats soulèvent la question d’un risque biologique plus élevé pour une catégorie importante de patients, et documente la notion de maladie métastatique précoce.
Les recommandations actuelles vont dans ce sens et notamment celle de l’ASCO (22). En effet, selon ces recommandations, la chirurgie première ne doit être envisagée qu’en l’absence de maladie métastatique évidente, chez des patients en bon état général avec un profil de comorbidité autorisant une prise en charge chirurgicale majeure, en l’absence de contact vasculaire significatif, et avec un taux de CA19-9 « acceptable ». Le seuil retenu est estimé entre 200 et 500 unités. Ces critères éliminent les situations borderline A, B et C précédemment citées.
Ces propositions reposent sur les résultats de plusieurs études s’étant intéressées au risque de récidive précoce après chirurgie, identifiant systématiquement les taux de CA19-9 pré-thérapeutiques comme prédictifs, avec des valeurs seuil fréquemment supérieur à 200 unités (23,24).
Pour aller plus loin dans le rationnel de maladie métastatique et de risque de récidive précoce, dans l’étude CLUSTER, Gemenetzis et al. ont rapporté que les patients ayant reçu une CT néoadjuvante présentaient un nombre total de cellules tumorales circulantes significativement plus faible que les patients non traités éligibles pour une résection d’emblée. Dans l’analyse de régression logistique multivariable, le nombre préopératoire de cellules tumorales circulantes était le seul facteur prédictif de récidive précoce après chirurgie, tant chez les patients naïfs de CT que chez les patients ayant reçu une CT néoadjuvante (18). Le contrôle de la maladie circulante doit donc être pris en considération.
IRM hépatique – élément majeur du bilan préthérapeutique
La détection des métastases, en particulier hépatiques, est une des priorités du bilan d’extension en raison de la fréquence de la maladie métastatique au diagnostic et du probable effet délétère de la laparotomie en cas de maladie métastatique méconnue en imagerie. En effet, environ 50 % des AP sont métastatiques au moment du diagnostic, environ 75 % des métastases sont hépatiques, 20 % pulmonaires et 10 % sont ganglionnaires à distance (25).
Une IRM hépatique avec imagerie en pondération de diffusion doit être réalisée systématiquement en cas de lésion résécable pour caractériser toute lésion atypique à la TDM (26) et rechercher des métastases hépatiques occultes, même en l’absence de lésion hépatique visible à la TDM (27,28). Dans la série de Kim HW et al., portant sur 167 patients, 32 % des lésions non caractérisées en TDM étaient des métastases en IRM. En cas de TDM hépatique normale, des métastases hépatiques sont détectées par l’IRM dans 5 à 10 % des cas, ce qui changeait la prise en charge thérapeutique (27,28).
À chaque stade, sa stratégie thérapeutique ?
Que dit la littérature ?
Résécable
Chirurgie première puis CT adjuvante
La résection chirurgicale en marge R0 est la pierre angulaire du traitement curatif de l’AP résécable. Il a été démontré que la CT adjuvante améliore la survie, et la chirurgie d’emblée suivie d’un traitement adjuvant reste le standard de soins pour tous les patients atteints d’un AP résécable. Cette approche est validée depuis les années 2000 avec les résultats de deux études de phases III randomisées (ESPAC-1 et CONKO-001), qui ont permis un doublement des taux de survie à 5 ans par l’utilisation du 5-FU ou de la gemcitabine, par rapport une stratégie de chirurgie seule (21 vs. 10 % et 21 vs. 8 %, respectivement) (29,30).
Depuis, 5 principaux essais randomisés ont permis d’améliorer les résultats oncologiques des patients opérés d’un AP résécable. Dans l’étude ESPAC-3 (31) qui a comparé 6 mois de CT adjuvante par 5FU ou par gemcitabine, les médianes de SG étaient respectivement de 23 et 23,6 mois. En 2017, l’essai ESPAC-4 a montré une augmentation de la SG à 28 mois versus 25,5 mois (p = 0,032) avec l’association gemcitabine-capecitabine versus gemcitabine seule (32). L’étude de phase III japonaise (JASPAC-01) qui a évalué le S1 dérivé oral du 5FU non commercialisé en France a montré la supériorité du S1 sur la gemcitabine en termes de SG à 5 ans (44,1 % contre 24,4 %) (33). Les résultats de l’étude française de phase III PRODIGE 24 ont montré la supériorité de la tri-CT par folfirinox modifié sur la gemcitabine seule chez les patients en bon état général (OMS 0 ou 1) avec une SG qui passait de 35 mois à 54,4 mois (HR = 0,64 ; p = 0,003) (34).
En 2019, l’essai APACT n’a pas réussi à montrer une supériorité sur son objectif primaire (Survie sans récidive) de l’association gemcitabine plus nab-paclitaxel par rapport à la gemcitabine seule. Mais lors de la mise à jour des résultats, avec un suivi médian de 63,2 mois, Tempero et al. ont rapporté, au congrès de l’ESMO en 2021, une médiane de SG de 41,8 mois avec l’association gemcitabine plus nab-paclitaxel contre 37,7 mois avec la gemcitabine seule [HR = 0,8 ; p = 0,0091]. Les taux de SG à 5 ans étaient de 38 % contre 31 %.
Malgré les progrès importants observés en termes de prise en charge péri-opératoire et de technique chirurgicale, la chirurgie d’exérèse pancréatique reste associée à des taux de morbidité pouvant atteindre 50 %. Ces complications peuvent être à l’origine d’un retard ou d’un défaut d’administration du traitement adjuvant. Il est ainsi communément admis que seuls 50 % à 60 % des patients reçoivent un traitement adjuvant après une résection pancréatique pour AP (5).
Dans une étude récente en situation réelle, Chikhaldze et al. ont observé que seulement 62 % des patients ont finalement reçu une CT adjuvante, et que seulement 60 % d’entre eux ont complété la séquence thérapeutique complète, ce qui correspond à 42 % de la population (35). Ainsi lorsque l’analyse est proposée en intention de traiter, à partir du diagnostic, la survie médiane globale après chirurgie première puis CT adjuvante n’est que de 14,8 mois, contre 18,8 mois après CT néoadjuvante (36).
Approche néoadjuvante
Les taux élevés de récidive à distance après une chirurgie pour un AP résécable soulignent le fait que la plupart des patients ont déjà une maladie systémique au moment du diagnostic. L’un des problèmes majeurs est l’identification de ces patients atteints d’une maladie métastatique occulte au diagnostic. Le concept de maladie systémique, déjà détaillé précédemment, est illustré dans l’étude CLUSTER qui a permis de mettre en évidence que 95 % des patients résécables avaient des cellules tumorales circulantes (CTC) dans leur sang périphérique et que les fluctuations des CTC étaient associées à la progression de la maladie et à la réponse au traitement (18). Compte tenu de ces données, l’administration d’un traitement systémique dans le cadre du traitement multimodal de l’AP est donc cruciale. L’administration d’un traitement systémique préopératoire permet d’optimiser l’accès à une séquence de traitement complète comme cela a été démontré en particulier dans l’étude PANACHE01- PRODIGE48. Et d’un point de vue oncologique, la réalisation de la séquence thérapeutique complète [(chirurgie + CT adjuvante) ou chimio(radio)thérapie néoadjuvante + chirurgie)] est clairement démontrée comme associée à une amélioration de la SG et sans récidive chez les patients présentant une maladie résécable (37).
Un autre rôle important du traitement préopératoire est de tester la biologie tumorale. Les patients qui ont des tumeurs agressives qui progressent et/ ou métastasent pendant la séquence néoadjuvante seraient épargnés d’une opération morbide alors considérée comme inutile. En plus de la sélection des patients présentant une biologie tumorale favorable, le traitement préopératoire permet de sélectionner les meilleurs candidats sur le plan de leur état général et physique. Les patients qui, en raison de leur état général (performance status), n’obtiennent pas de bons résultats avec le traitement systémique, auront probablement aussi de mauvais résultats avec la chirurgie. Chez ces patients présentant un AP résécable mais qui ne sont pas de bons candidats à la chirurgie du fait de leur état nutritionnel et physique, le traitement préopératoire permet d’optimiser leur état médical et/ ou physique avant l’opération. De nombreux centres utilisent désormais des programmes de rééducation préopératoire de routine (préhabilitation) avec des résultats prometteurs. Le traitement préopératoire peut potentiellement conduire à un downsizing/downstaging tumoral et est associé à des taux plus faibles de positivité des marges et de l’envahissement ganglionnaire (38).
Dans le cas de lésions indéterminées, suspectes, non accessibles à une biopsie, le traitement préopératoire permet de surveiller ces lésions et de tester la maladie. Pour les patients qui progressent, les taux de laparotomie exploratrice peuvent être réduits.
Le traitement préopératoire n’est pas sans limites. Tout d’abord, pour proposer un traitement néoadjuvant, un diagnostic histologique doit être obtenu. En raison du stroma dense associé à ces tumeurs, la confirmation tissulaire peut être difficile, et chez environ 15 % des patients, la confirmation tissulaire reste un échec, même lorsque les biopsies sont réalisées par un endoscopiste compétent (39). Les opposants à la stratégie néoadjuvante invoquent le risque de progression locale où les patients pourraient perdre leur « fenêtre pour la chirurgie ». Cependant, ce concept n’est pas tout à fait exact, car la progression locale se produit presque toujours en même temps que le développement de la maladie systémique.
Un autre problème potentiel est que les patients qui présentent une obstruction biliaire doivent être drainés à l’aide d’une endoprothèse biliaire, ce qui n’est pas sans morbidité. L’endoprothèse et les complications liées à l’endoprothèse peuvent retarder le traitement, retarder la chirurgie et entraîner des complications péri-opératoires plus importantes en raison de la contamination biliaire bactérienne. Cependant, l’utilisation d’une endoprothèse métallique courte, qui permet l’obtention d’une perméabilité à plus long terme avec moins de complications et un retrait facile au moment de l’opération, permet de limiter ces problèmes.
Tous ces avantages/ inconvénients de l’approche néoadjuvante ont été explorés par des essais contrôlés randomisés qui ont validé la faisabilité de la séquence néoadjuvante, et son intérêt oncologique (sélection des patients, downstaging, survie). (tableau 2). Trop peu d’études de phase 3 sont encore disponibles pour positionner l’approche néoadjuvante comme standard thérapeutique pour l’AP résecable. Pour autant les données disponibles (Essais thérapeutiques randomisés PANACHE01-PRODIGE48, NEONAX, SWOG1505, Preop-02/ JSAP-05, PREOPANC1), positionnent actuellement la CT et en particulier le mFOLFIRINOX en France, comme une option de traitement pour l’AP résécable.
Les principales études en cours et en attente (PREOPANC-3, Alliance A021806, et PANACHE02. PREOPANC-3 et Alliance A021806) sont 2 études de phase III randomisées de design équivalents comparant une CT mFOLFIRINOX utilisée en préopératoire (8 cycles) vs. post-opératoire (12 cycles).
L’étude PANACHE02, financée au PHRC-K en 2021, en attente de lancement, va évaluer l’intérêt d’un switch de CT en situation adjuvante en cas de défaut de réponse après 6 cycles mFOLFIRINOX néoadjuvant.
| Étude | | | | | | | | |
| | Bras 1: Preoperave Gem + RT
Bras 2: Surgery First and Postoperave Gem | | 246
bras 1: 119 bras 2: 127 Resecable: 133
(bras 1: 65, bras 2: 68) Borderline: 113
(bras 1: 54, bras 2: 59) | SG (ITT)
bras 1: 16.0mo bras 2: 14.3mo (HR 0.78; 95% CI, 0.58 to 1.05; p = .096) Resecable: bras 1: 14.6mo, bras 2: 15.6mo, (HR 0.96, 95% CI 0.64-1.44; p=0.830) Borderline: bras 1: 17.6mo, bras 2: 13.2mo, (HR 0.62, 95% CI 0.40-0.95; p=0.029 | SSM
Bras 1: 8.1mo bras 2: 7.7mo (HR 0.73 95% CI 0.55-0.96; p=0.032)
Resecable
Bras 1: 9.2mo, bras 2: 9.3mo (HR 0.88, 95% CI, 0.60-1.28; p=0.520)
Borderline
Bras: 6.3mo,
Bras 2: 6.2mo (HR 0.59, 95% CI 0.39-0.89; p=0.013) | Bras 1: 61%
Bras 2: 72%
Resecable
Bras 1: 68%
Bras 2: 79% (OR 0.54, 95% CI 0.25-1.19, p=0.170)
Borderline
Bras 1: 52%
Bras 2: 64% (OR 0.60, 95% CI 0.28-1.27, p=0.190 | Bras 1: 71%
Bras 2: 40%
Resecable
Bras 1: 66%
Bras 2: 59% (OR 1.33, 95% CI 0.58-3.04, p=0.540)
Borderline
Bras 1: 79%
Bras 2: 13% (OR 24.20, 95% CI 6.57-89.12, p=0.001) |
| Phase II randomisée “pick the winner” design | Bras 1: Preoperave mFOLFIRINOX
Bras 2: Preoperave GP | | 147
Bras 1: 55 Bras 2: 47 | SG à 2ans
Bras 1: 47% (95% CI, 31%- 61%; p=0.15) Bras 2: 48% (95% CI, 31%- 63%; p=0.14) 23.6mo Comparaison au groupe contrôle historique de 40% | SSM
Bras 1: 10.9mo
Bras 2: 14.2mo (p=0.86) | | Bras 1: 85%
Bras 2: 85% p>0.99 |
PANACHE01- PRODIGE48 (France) | | Bras 1: mFOLFIRINOX néoadjuvant
Bras 2: FOLFOX neoadjuvant | | | Cocritère de jugement -Survie globale à 1 an et taux de réalisation de la séquence complète Bras 1: 84,1%/88,6% Bras 2: 71,8%/84% | | | |
| | Bras 1: gemcitabine/ nab-paclitaxel périopératoire
Bras 2: gemcitabine/ nab-paclitaxel | | | Taux de SSM prédéfini de 55% à 18 mois non atteint dans les deux bras Bras 1:33,3% [95%CI 18,5- 48,1], Bras 2:41,4% [95%CI 20,7-62,0]) | SG médiane
de Bras 1:
25,5 mois. [IC95% : 19,7- 29,7]
Bras 2: 16,7mo. [IC95% : 11,6-22,2] dans le bras de chirurgie initiale. | | |
Preop-02/ JSAP-05 (Japon) | | Bras 1: gemcitabine/S-1 néoadjuvant (2 cycles)
Bras 2: chirurgie d’emblée,
6 mois de S-1 adjuvant dans les 2 bras | | | SG médiane de 37 vs 27 mois (HR = 0,72, IC 95 % : 0,55- 0,94, p = 0,015) | Absence de différence en terme de taux de résection, taux de résection R0 et morbidité | | |
Tableau 2 : Synthèse des études prospectives récentes évaluant l’intérêt du traitement néoadjuvant pour AP résécable
Borderline
La prise en charge oncologique de l’AP borderline est actuellement bien standardisée concernant la nécessité en première intention d’un traitement dit « d’induction ». Bien que la prise en charge chirurgicale première soit longtemps restée une option pour la prise en charge des lésions borderline, l’étude ESPAC-5F permet à présent de clore le débat. En effet les taux de survie globale à 12 mois était de 42 % dans le groupe chirurgie première et de 77 % en combinant les différentes modalités de traitement néoadjuvant proposées dans cette étude.
Si l’on s’intéresse à la revue systématique de la littérature de Verteijne et al. incluant 25 études et 2 133 patients avec AP borderline, on note des médianes de SG significativement supérieures en faveur d’un traitement d’induction avec 19,2 mois contre 12,8 mois, et le taux d’exérèse R0 était de 88,6 % dans le groupe traitement d’induction contre 63,5 % (36).
Dans l’étude de Janssen et al. rapportant 258 patients avec un AP borderline pris en charge en intention de traiter, le taux de résection après CT induction était de 78,4 % avec un taux de résection R0 de 87,5 %. Après un suivi médian de 22 mois, la médiane de survie globale était de 24,1 mois et les médianes de survie sans récidive était de 18,1 mois. Avec ces résultats, les résultats oncologiques se rapprochent de ceux de l’AP résécable opérés d’emblée (40).
Plusieurs questions restent ouvertes actuellement : quelles modalités de CT optimale peuvent être proposées (FOLFIRINOX, Gemcitabine-NabPaclitaxel) ; quelle est la durée optimale de traitement d’induction (place du traitement préoperatoire total) ; y a-t-il un intérêt à une radio CT et selon quelles modalités (radio CT conventionnelle ? radiothérapie stéréotaxique ? protonthérapie ?).
Les différents essais thérapeutiques en cours ou en attente de lancement permettront de répondre en partie à ces questions (tableau 3).

Figure 5 : AP borderline avant et après 6 cycles de chimiothérapie par mFOLFIRINOX. Réponse RECIST, avec persistance des contacts vasculaires
Localement avancé
Le traitement de référence pour l’AP localement avancé est la CT. La gemcitabine reste la CT la mieux validée dans ce contexte, sur la base des résultats d’études antérieures concernant des patients présentant des tumeurs métastatiques et localement avancées. L’ajout d’erlotinib à la gemcitabine n’a pas amélioré la survie dans l’étude de phase III LAP07 (41).
Compte tenu de leur efficacité en situation métastatique, les CTs à base de FOLFIRINOX et de gemcitabine plus nab-paclitaxel ont été testés chez les patients atteints d’AP localement avancé, avec des résultats intéressants. L’étude de Suker et al. a évalué par une méta-analyse incluant 355 patients avec un AP localement avancé l’efficacité d’une CT à base de FOLFIRINOX en première ligne de traitement. Les médianes de SG et de survies sans progression à partir du début du traitement par FOLFIRINOX étaient de 24,2 mois et 15 mois, respectivement. Le profil de toxicité était concordant avec les données de la littérature à savoir un taux d’événements indésirables de grade 3 et 4 de 60 %. Aucun décès n’était attribué à une toxicité de la CT. 57 % des patients inclus étaient traités par radiothérapie ou RCT complémentaire et 26 % des patients étaient opérés secondairement avec un taux de résection R0 de 78,4 % (42). Néanmoins, il aura fallu attendre les résultats de l’étude NEOPAN pour obtenir des données comparatives à la Gemcitabine. Le critère de jugement principal était la survie sans progression, de 9,7 mois dans le bras FOLFIRINOX contre 7,5 mois dans le bras de référence (Gemcitabine) (p < 0,03). L’étude NEOPAN est donc positive sur son critère de jugement principal et le FOLFIRINOX constitue une option valide en situation d’AP localement avancé. Néanmoins, il n’existait pas de bénéfice en SG malgré une proportion plus importante de patients dans le bras FOLFIRINOX qui ont pu recevoir une CT d’entretien, accéder à un traitement local de type radiothérapie ou RCT avant progression, et recevoir une CT de 2e ligne après progression. Seuls 4 % des patients ont été opérés, identifiant, une population strictement non résécable au diagnostic. La clarté des définitions de résécabilité doit être soulignée pour rendre les résultats des études comparables entre elles.
Le rationnel de la RCT dans la gestion des AP localement avancé n’est pas consensuel. L’étude randomisée de phase III LAP07 n’a pas montré de supériorité de la RCT sur la poursuite de la CT initiale seule en termes de SG (41). Une analyse secondaire a montré que l’administration d’une RCT était associée à un meilleur contrôle local et à une période sans traitement plus longue. Ainsi, la RCT est actuellement proposée comme une option après une CT d’induction de trois à six mois (afin d’exclure les patients présentant une progression métastatique rapide). Devant les résultats encore débattus de la RCT de clôture, l’étude CONKO 007 a comparé une CT d’induction suivie d’une RCT à une CT seule pour les AP localement avancés non résécables. Les premiers résultats rapportés à l’ASCO 2022 indiquent que la RCT diminue le taux de résection R1 mais n’augmente pas le taux de résection chirurgicale (36 % dans les 2 bras, étude négative sur son critère de jugement principal) et n’augmente pas la survie (ni la SSP ni la SG), comme dans l’essai LAP07. La chirurgie, quand elle est possible avec des marges négatives, est le meilleur facteur pronostique, que les patients aient reçu une CT seule ou l’association CT/RCT. L’intérêt d’une RCT après CT d’induction reste à démontrer à l’ère du FOLFIRINOX et une meilleure sélection des patients susceptibles d’en tirer un bénéfice reste nécessaire.
Ainsi, la RCT est une option à discuter lors des RCP chez les patients dont la maladie est contrôlée après une CT d’induction, en particulier lorsqu’une pause thérapeutique est envisagée.
| | | | | | | | |
| | Bras 1: Radiochimio 45Gy (Gemcitabine) preop Bras 2: Radiochimio 45Gy (Gemcitabine) postop | | | 2 year OS
Bras 1: 41%
Bras 2: 26%, (HR 1.97, 95% CI 1.073.62, p=0.028 | Taux de récidive
Bras 1: 88.2%
Bras 2: 88.9% | | Bras 1: 52%
Bras 2: 26% p=0.004 |
| | mFOLFIRINOX Radiochimio preop | | 29 preenregistré
23 retenu après relecture centralisée
22 initiation traitement | Faisabilité SG 21.7 mo (95% CI 15.7 non atteinte) | | | |
| | mFOLFIRINOX Radiochimio preop | | | | SG 37.7 mo (95%CI, 19.4 to non atteint)
SSM 14.7 mo (95%CI, 10.5 to non atteint) | | |
Alliance A021501 41,51 (US) | | Bras 1: mFOLFIRINOX preop
Bras 2: mFOLFIRINOX preop + RT stéréo | | 126
Bras 1: 70
Bras 2: 56 | 18 mo SG
Bras 1: 66% (SG 29.8mo)
Bras 2: 47% (SG 17.1mo) | SSM
Bras 1: 15.0mo
Bras 2: 10.2 mo | ITT:
Bras 1: 46%
Bras: 34% Parmi les patients amenés au projet chirurgical
Bras 1: 84%
Bras 2: 68% | Parmi les patients opérés: Bras 1: 88%
Bras 2: 74% |
| | Bras 1: Chirurgie d’emblée
Bras 2: GEMCAP preop Bras 3: FOLFIRINOX preop
Arm 4: Radiochimio preop | | 90
Bras 1: 32
Bras 2: 20
Bras 3: 20
Bras 4: 16 | Taux d’inclusion
21 patients/an | Sg à 1 an
Bras 1: 40% (95% CI, 26%- 62%)
Bras 2-4 (neoadjuvant): 77% (95%CI, 66%-89%) | Bras 1: 62%
Bras 2-4 (neoadjuvant): 55% (p=0.668) | Bras 1: 15%
Bras 2-4 (neoadjuvant): 23% (p=0.721) |
PREOPANC-1 (voir tableau précédent) | | | | | | | | |
| | Bras 1: chimiothérapie preopératoire totale mFOLFIRINOX Bras 2: Radiochimio 45Gy (Gemcitabine) + Gemcitabine postop | Ouverte en 2018 Fin d’étude estimée en 2023 | | | | | |
PANDA- PRODIGE44 (France) | | Bras 1: mFOLFIRINOX preop Bras 2: mFOLFIRINOX + Radiochimiothérapie preop | | | | | | |
Tableau 3 : Synthèse des études prospectives récentes comparant les stratégies d’induction pour AP borderline
Que disent les recommandations ?
Résécable
Les recommandations de l’ASCO ou du NCCN, prenant en considération le risque biologique en particulier, ne proposent une chirurgie d’emblée (8,22),
- qu’en l’absence de maladie métastatique évidente, après un bilan exhaustif incluant un scanner TAP et une IRM hépatique ;
- chez des patients en bon état général avec un profil de comorbidité autorisant une prise en charge chirurgicale majeure ;
- en l’absence de contact vasculaire ;
- avec un taux de CA 19-9 acceptable (seuil retenu à 200 unités).
Les recommandations françaises, selon le TNCD, ne sont pas si précises et proposent en première intention la chirurgie d’emblée, devant le défaut de résultats d’étude de phase III en faveur du traitement systémique premier. Le traitement adjuvant de référence est le FOLFIRINOX modifié, avec en alternative l’association Gemcitabine-Capecitabine.
L’inclusion dans les essais cliniques doit être privilégiée. L’étude PANACHE02, devrait ouvrir aux inclusions en 2023.
Borderline
Les recommandations internationales et françaises sont en faveur d’un traitement systémique premier, dit d’induction, dans l’intention d’une chirurgie secondaire pour AP borderline. Le traitement de référence est une CT à base de FOLFIRINOX modifié, d’une durée de 3 mois. Aucune distinction n’est faite selon le caractère veineux ou artériel de l’envahissement, quant à la RCT complémentaire qui est une option. L’étude PANDA, dont les inclusions sont terminées depuis novembre 2022, permettra de positionner la RCT dans la prise en charge des AP borderline.
L’étude NEOPROPANC-01, proposant un traitement néoadjuvant complet incluant une CT suivie d’une RCT en comparaison à une protonthérapie avec modulation d’intensité suivie d’une chirurgie chez des patients porteurs d’un AP borderline devrait ouvrir aux inclusions en 2023.
Localement avancé
Bien que non prise en considération dans les référentiels, se distinguent actuellement des atteintes localement avancées dites « jamais résécables » d’autres potentiellement résécables, pour lesquels les objectifs vont être distincts, comme cela est souligné par les discordances en termes d’accès à la chirurgie entre les études CONKO 007 et NEOPAN (36 vs. 4 %). Dans la première situation le contrôle locorégional et la qualité de vie sont en première ligne. Une CT par gemcitabine ou FOLFIRINOX est recommandée. En situation d’AP potentiellement résécable, chez des patients en bon état général, une CT d’induction (mFOLFIRINOX) selon le même format que les AP borderline peut être proposée en option selon le TNCD. La place de la RCT de clôture est à discuter au cas par cas. La place de la RCT de consolidation peut également être discutée dans une intention de chirurgie, au regard des taux de réponse pathologique complète significativement supérieurs dans l’étude rétrospective française de l’AGEO (16,7 % après RCT) et la survie prolongée observée de 48 mois dans ce sous-groupe (43).
Quelle place pour la résection chirurgicale après traitement d’induction ?
Le risque de progression de la maladie en cours de traitement d’induction reste un point majeur dans l’orientation des patients vers le projet chirurgical. Il est donc essentiel de renouveler les examens biologiques et radiologiques en particulier en fin de traitement d’induction. Les modalités précises guidant la décision ne sont pas consensuelles et surtout les examens discriminants en particulier sur le plan morphologique ne sont actuellement pas suffisamment précis.
La classification de réponse clinique biologique et morphologique après traitement d’induction proposé par Evans et al. est simple et facilement utilisable en pratique clinique (tableau 4).
La situation la plus simple concerne l’amélioration de l’état général du patient et en particulier la régression ou disparition des symptômes douloureux, la régression ou la réponse selon RECIST sur les données d’imagerie et une normalisation du taux de CA 19-9 en particulier. On considéra ce groupe de patients comme « bon répondeur » qui devront être candidats pour une exérèse chirurgicale. À l’opposé les patients « non répondeurs » seront ceux pour lesquels il n’est pas observé d’amélioration de l’état clinique, une progression sur le plan morphologique localement ou à distance et une progression des marqueurs tumoraux. Ainsi, aucune exploration chirurgicale ne devrait être proposée à ce groupe de patients. En situation de stabilité de la maladie selon le souhait du patient et l’expérience du chirurgien qui le prendra en charge une exploration chirurgicale doit être proposée de manière à évaluer la résécabilité en per-opératoire.
Données biologiques
L’évaluation de la réponse biologique est principalement marquée par l’utilisation des fluctuations du taux de CA 19 mais les critères analysés dans la littérature sont variables. Certains définissent une réponse majeure soit par une diminution du taux de CA 19-9 supérieure à 90 % soit une normalisation du taux de CA 19-9 quelle que soit la valeur au diagnostic. Dans l’étude du MDA Anderson rapporté par Tzeng en 2014 la normalisation du taux de CA 19-9 était un facteur prédictif de SG en analyse multivariée avec un Hazard ratio à 2,13 (44). La normalisation du taux de CA 19-9 parmi les patients opérés secondairement permettait l’obtention d’une médiane de SG à 37,9 mois contre 26 mois. Dans l’étude de Takashi en 2010, la SG à 4 ans selon la réponse était assez indicatif avec en situation de réponse majeure un taux de survie global à 4 ans de 58,9 %, en cas de réponse mineure de 34,20 %, et en l’absence de réponse aucun patient n’était vivant à 4 ans (45).
Plus récemment l’équipe d’Heidelberg a rapporté un taux de CA 19-9 inférieur à 100 unités après traitement néoadjuvant/ d’induction comme prédictif de resécabilité secondaire avec un odds ratio à 11 (46).
Les données concernant le ratio neutrophiles sur lymphocytes sont hétérogènes dans la littérature et n’autorisent actuellement pas son utilisation de manière isolée pour la décision thérapeutique. Concernant les patients Lewis négatifs, pour lesquels le CA 19-9 n’est pas interprétable, le ratio neutrophiles sur lymphocytes pourrait être intéressant avec un seuil à 2,62 comme le rapportait en 2020 Liu et al. (47) mais ces résultats sont encore à confirmer.
Données radiologiques
Les données de la littérature concernant l’efficacité du scanner pour déterminer les possibilités de résection chirurgicale après traitement néoadjuvant sont à peu près toutes concordantes (48-50). Autant le scanner est précis en termes de prédiction de la résécabilité R0 avant chirurgie (efficacité de prédiction supérieure à 80 %) autant il est peu spécifique après traitement d’induction (efficacité de prédiction < 60 %). Dans l’étude de Cassinoto et al. il était mentionné une surestimation de la taille avec une variabilité de 10 mm après traitement d’induction et 12 des 31 patients évalué avec risque de résection R1 sur les données scanographiques étaient finalement R0 après traitement d’induction (48). Ainsi il était conclu que seule l’exploration chirurgicale permettait de conclure sur le statut de résection. Le bilan de réévaluation morphologique doit donc s’intéresser à la taille tumorale mais aussi et surtout à l’interface entre la tumeur et les vaisseaux en évaluant la longueur de l’interface tumorale, le degré d’atteinte circonférentielle et les contours vasculaires avec ou sans déformation (51).
Données métaboliques
En raison de sa faible disponibilité et de son coût la tomographie par émission de positon n’est encore que peu utilisée en France dans l’évaluation de la réponse après traitement d’induction pour AP localisé. Certaines études et en particulier celle de Panda et al. (52) indique une prédiction de la réponse pathologique complète ou de la survie très bien corrélée avec les données de variation de SUV-max ou de volume métabolique. Aucune recommandation ne peut pour autant être faite sur les données actuelles de la littérature. Dans l’étude récente de Akita et al. sur une cohorte prospective de 141 patients, le taux de SG à 5 ans des patients présentant une réponse métabolique était de 46 % versus 25 % en l’absence de réponse. Les auteurs ont également identifié de manière significative des taux de récidive locorégionale significativement inférieurs dans le groupe réponse métabolique. Ces résultats intéressants devront être confirmés dans le cadre d’essais de plus grande ampleur.
Tableau 4 | | | |
État général incluant l’évaluation de la douleur | | | |
Imagerie de la tumeur primitive (TDM, IRM, TEP…) | Amélioration ou absence de progression | | Progression locale ou à distance |
Profil biologique, biomarqueurs (CA 19-9 +/- autres biomarqueurs pertinents) | Evoque une réponse au traitement (exemple : normalisation du taux de CA 19-9 ou autres marqueurs pertinents) | | Evoque une progression
de la maladie (exemple : augmentation du taux de CA 19-9) |
Comment utiliser les informations ci dessus | Les 3 indicateurs doivent évoquer une réponse → CHIRURGIE D’EXERESE | Les 3 indicateurs doivent indiquer uns stabilité de la maladide → EXPLORATION CHIRURGICALE | n’importe lequel de ces trois éléments définit une absence de réponse → ABSENCE DE PROJET CHIRURGICAL |
Conclusion
Peu de patients présentant un AP auront accès à un traitement potentiellement curatif. Il est ainsi nécessaire d’identifier ces patients et de les traiter de manière adaptée. Il est essentiel d’identifier les patients présentant un AP résécable d’emblée, sans méconnaître une maladie potentiellement micrométastatique (borderline B). Le traitement néoadjuvant est une approche intéressante pour optimiser les résultats oncologiques et la sélection des meilleurs candidats à la chirurgie. Concernant les patients atteints d’un AP borderline anatomique, la stratégie de traitement d’induction aura pour principal objectif d’optimiser les chances de résection R0. La radiochimiothérapie complémentaire est en cours d’évaluation. Les patients présentant un AP localement avancé, sont rarement candidats à la chirurgie, mais l’optimisation du traitement d’induction (chimiothérapie agressive avec ou sans radiochimiothérapie) et la réévaluation de la réponse régulière peut permettre des survies prolongées. La centralisation de l’expertise de l’évaluation de la réponse pour optimiser les chances de prise en charge chirurgicale après traitement d’induction doit se discuter au cas par cas.
Références
- Siegel RL, Miller KD, Fuchs HE, Jemal A. Cancer Statistics, 2021. CA Cancer J Clin. janv 2021;71(1):7-33.
- Oettle H, Neuhaus P, Hochhaus A, Hartmann JT, Gellert K, Ridwelski K, et al. Adjuvant Chemotherapy With Gemcitabine and Long-term Outcomes Among Patients With Resected Pancreatic Cancer: The CONKO-001 Randomized Trial. JAMA. 9 oct 2013;310(14):1473.
- Delpero JR, Bachellier P, Regenet N, Le Treut YP, Paye F, Carrere N, et al. Pancreaticoduodenectomy for pancreatic ductal adenocarcinoma: a French multicentre prospective evaluation of resection margins in 150 evaluable specimens. HPB. janv 2014;16(1):20-33.
- Chang DK, Johns AL, Merrett ND, Gill AJ, Colvin EK, Scarlett CJ, et al. Margin Clearance and Outcome in Resected Pancreatic Cancer. JCO. 10 juin 2009;27(17):2855-62.
- Merkow RP, Bilimoria KY, Tomlinson JS, Paruch JL, Fleming JB, Talamonti MS, et al. Postoperative Complications Reduce Adjuvant Chemotherapy Use in Resectable Pancreatic Cancer. Annals of Surgery. août 2014;260(2):372-7.
- Raut CP, Tseng JF, Sun CC, Wang H, Wolff RA, Crane CH, et al. Impact of Resection Status on Pattern of Failure and Survival After Pancreaticoduodenectomy for Pancreatic Adenocarcinoma. Annals of Surgery. juill 2007;246(1):52-60.
- Zhang B, Lee GC, Qadan M, Fong ZV, Mino-Kenudson M, Desphande V, et al. Revision of Pancreatic Neck Margins Based on Intraoperative Frozen Section Analysis Is Associated With Improved Survival in Patients Undergoing Pancreatectomy for Ductal Adenocarcinoma. Ann Surg. 1 août 2021;274(2):e134-42.
- Tempero MA, Malafa MP, Al-Hawary M, Behrman SW, Benson AB, Cardin DB, et al. Pancreatic Adenocarcinoma, Version 2.2021, NCCN Clinical Practice Guidelines in Oncology. J Natl Compr Canc Netw. 1 avr 2021;19(4):439-57.
- Lu DS, Reber HA, Krasny RM, Kadell BM, Sayre J. Local staging of pancreatic cancer: criteria for unresectability of major vessels as revealed by pancreatic-phase, thin-section helical CT. AJR Am J Roentgenol. juin 1997;168(6):1439-43.
- Mehta VK, Fisher G, Ford JA, Poen JC, Vierra MA, Oberhelman H, et al. Preoperative chemoradiation for marginally resectable adenocarcinoma of the pancreas. J Gastrointest Surg. 2001;5(1):27-35.
- Tran Cao HS, Balachandran A, Wang H, Nogueras-González GM, Bailey CE, Lee JE, et al. Radiographic Tumor–Vein Interface as a Predictor of Intraoperative, Pathologic, and Oncologic Outcomes in Resectable and Borderline Resectable Pancreatic Cancer. J Gastrointest Surg. févr 2014;18(2):269-78.
- Varadhachary GR, Tamm EP, Abbruzzese JL, Xiong HQ, Crane CH, Wang H, et al. Borderline resectable pancreatic cancer: definitions, management, and role of preoperative therapy. Ann Surg Oncol. août 2006;13(8):1035-46.
- Bockhorn M, Uzunoglu FG, Adham M, Imrie C, Milicevic M, Sandberg AA, et al. Borderline resectable pancreatic cancer: A consensus statement by the International Study Group of Pancreatic Surgery (ISGPS). Surgery. juin 2014;155(6):977-88.
- Isaji S, Mizuno S, Windsor JA, Bassi C, Fernández-del Castillo C, Hackert T, et al. International consensus on definition and criteria of borderline resectable pancreatic ductal adenocarcinoma 2017. Pancreatology. janv 2018;18(1):2-11.
- Al-Hawary MM, Francis IR, Chari ST, Fishman EK, Hough DM, Lu DS, et al. Pancreatic ductal adenocarcinoma radiology reporting template: consensus statement of the Society of Abdominal Radiology and the American Pancreatic Association. Radiology. janv 2014;270(1):248-60.
- Baxter NN, Whitson BA, Tuttle TM. Trends in the treatment and outcome of pancreatic cancer in the United States. Ann Surg Oncol. avr 2007;14(4):1320-6.
- Groot VP, Gemenetzis G, Blair AB, Rivero-Soto RJ, Yu J, Javed AA, et al. Defining and Predicting Early Recurrence in 957 Patients With Resected Pancreatic Ductal Adenocarcinoma. Annals of Surgery. juin 2019;269(6):1154-62.
- Gemenetzis G, Groot VP, Yu J, Ding D, Teinor JA, Javed AA, et al. Circulating Tumor Cells Dynamics in Pancreatic Adenocarcinoma Correlate With Disease Status: Results of the Prospective CLUSTER Study. Annals of Surgery. sept 2018;268(3):408-20.
- Schwarz L, Katz MHG. Diagnosis and Management of Borderline Resectable Pancreatic Adenocarcinoma. Hematol Oncol Clin North Am. août 2015;29(4):727-40.
- Schwarz L, Vernerey D, Bachet JB, Tuech JJ, Portales F, Michel P, et al. Resectable pancreatic adenocarcinoma neo-adjuvant FOLF(IRIN)OX-based chemotherapy – a multicenter, non-comparative, randomized, phase II trial (PANACHE01-PRODIGE48 study). BMC Cancer. 24 juill 2018;18(1):762.
- Sohal DP, Walsh RM, Ramanathan RK, Khorana AA. Pancreatic Adenocarcinoma: Treating a Systemic Disease With Systemic Therapy. JNCI Journal of the National Cancer Institute. 26 mars 2014;106(3):dju011-dju011.
- Khorana AA, McKernin SE, Berlin J, Hong TS, Maitra A, Moravek C, et al. Potentially Curable Pancreatic Adenocarcinoma: ASCO Clinical Practice Guideline Update. J Clin Oncol. 10 août 2019;37(23):2082-8.
- Ishido K, Kimura N, Wakiya T, Nagase H, Hara Y, Kanda T, et al. Development of a Biomarker-Based Scoring System Predicting Early Recurrence of Resectable Pancreatic Duct Adenocarcinoma. Ann Surg Oncol. févr 2022;29(2):1281-93.
- Daamen LA, Dorland G, Brada LJH, Groot VP, van Oosten AF, Besselink MG, et al. Preoperative predictors for early and very early disease recurrence in patients undergoing resection of pancreatic ductal adenocarcinoma. HPB (Oxford). 24 sept 2021;S1365-182X(21)01624-5.
- Oweira H, Petrausch U, Helbling D, Schmidt J, Mannhart M, Mehrabi A, et al. Prognostic value of site-specific metastases in pancreatic adenocarcinoma: A Surveillance Epidemiology and End Results database analysis. World J Gastroenterol. 14 mars 2017;23(10):1872-80.
- Jeon SK, Lee JM, Joo I, Lee DH, Ahn SJ, Woo H, et al. Magnetic resonance with diffusion-weighted imaging improves assessment of focal liver lesions in patients with potentially resectable pancreatic cancer on CT. Eur Radiol. août 2018;28(8):3484-93.
- Kim HW, Lee JC, Paik KH, Kang J, Kim YH, Yoon YS, et al. Adjunctive role of preoperative liver magnetic resonance imaging for potentially resectable pancreatic cancer. Surgery. juin 2017;161(6):1579-87.
- Marion-Audibert AM, Vullierme MP, Ronot M, Mabrut JY, Sauvanet A, Zins M, et al. Routine MRI With DWI Sequences to Detect Liver Metastases in Patients With Potentially Resectable Pancreatic Ductal Carcinoma and Normal Liver CT: A Prospective Multicenter Study. American Journal of Roentgenology. nov 2018;211(5):W217-25.
- Neoptolemos J, Dunn J, Stocken D, Almond J, Link K, Beger H, et al. Adjuvant chemoradiotherapy and chemotherapy in resectable pancreatic cancer: a randomised controlled trial. The Lancet. nov 2001;358(9293):1576-85.
- Oettle H, Post S, Neuhaus P, Gellert K, Langrehr J, Ridwelski K, et al. Adjuvant Chemotherapy With Gemcitabine vs Observation in Patients Undergoing Curative-Intent Resection of Pancreatic Cancer: A Randomized Controlled Trial. JAMA. 17 janv 2007;297(3):267.
- Neoptolemos JP, Stocken DD, Bassi C, Ghaneh P, Cunningham D, Goldstein D, et al. Adjuvant Chemotherapy With Fluorouracil Plus Folinic Acid vs Gemcitabine Following Pancreatic Cancer Resection: A Randomized Controlled Trial. JAMA. 8 sept 2010;304(10):1073.
- Neoptolemos JP, Palmer DH, Ghaneh P, Psarelli EE, Valle JW, Halloran CM, et al. Comparison of adjuvant gemcitabine and capecitabine with gemcitabine monotherapy in patients with resected pancreatic cancer (ESPAC-4): a multicentre, open-label, randomised, phase 3 trial. The Lancet. mars 2017;389(10073):1011-24.
- Uesaka K, Boku N, Fukutomi A, Okamura Y, Konishi M, Matsumoto I, et al. Adjuvant chemotherapy of S-1 versus gemcitabine for resected pancreatic cancer: a phase 3, open-label, randomised, non-inferiority trial (JASPAC 01). Lancet. 16 juill 2016;388(10041):248-57.
- Conroy T, Hammel P, Hebbar M, Ben Abdelghani M, Wei AC, Raoul JL, et al. FOLFIRINOX or Gemcitabine as Adjuvant Therapy for Pancreatic Cancer. N Engl J Med. 20 déc 2018;379(25):2395-406.
- Chikhladze S, Lederer AK, Kousoulas L, Reinmuth M, Sick O, Fichtner-Feigl S, et al. Adjuvant chemotherapy after surgery for pancreatic ductal adenocarcinoma: retrospective real-life data. World J Surg Onc. déc 2019;17(1):185.
- Versteijne E, Vogel JA, Besselink MG, Busch ORC, Wilmink JW, Daams JG, et al. Meta-analysis comparing upfront surgery with neoadjuvant treatment in patients with resectable or borderline resectable pancreatic cancer. British Journal of Surgery. 14 juin 2018;105(8):946-58.
- Tzeng CWD, Cao HST, Lee JE, Pisters PWT, Varadhachary GR, Wolff RA, et al. Treatment Sequencing for Resectable Pancreatic Cancer: Influence of Early Metastases and Surgical Complications on Multimodality Therapy Completion and Survival. J Gastrointest Surg. janv 2014;18(1):16-25.
- Schorn S, Demir IE, Reyes CM, Saricaoglu C, Samm N, Schirren R, et al. The impact of neoadjuvant therapy on the histopathological features of pancreatic ductal adenocarcinoma – A systematic review and meta-analysis. Cancer Treatment Reviews. avr 2017;55:96-106.
- Kitano M, Yoshida T, Itonaga M, Tamura T, Hatamaru K, Yamashita Y. Impact of endoscopic ultrasonography on diagnosis of pancreatic cancer. J Gastroenterol. janv 2019;54(1):19-32.
- Janssen QP, van Dam JL, Doppenberg D, Prakash LR, van Eijck CHJ, Jarnagin WR, et al. FOLFIRINOX as Initial Treatment for Localized Pancreatic Adenocarcinoma: A Retrospective Analysis by the Trans-Atlantic Pancreatic Surgery (TAPS) Consortium. J Natl Cancer Inst. 14 févr 2022;djac018.
- Hammel P, Huguet F, van Laethem JL, Goldstein D, Glimelius B, Artru P, et al. Effect of Chemoradiotherapy vs Chemotherapy on Survival in Patients With Locally Advanced Pancreatic Cancer Controlled After 4 Months of Gemcitabine With or Without Erlotinib: The LAP07 Randomized Clinical Trial. JAMA. 3 mai 2016;315(17):1844-53.
- Suker M, Beumer BR, Sadot E, Marthey L, Faris JE, Mellon EA, et al. FOLFIRINOX for locally advanced pancreatic cancer: a systematic review and patient-level meta-analysis. The Lancet Oncology. juin 2016;17(6):801-10.
- Pietrasz D, Turrini O, Vendrely V, Simon JM, Hentic O, Coriat R, et al. How Does Chemoradiotherapy Following Induction FOLFIRINOX Improve the Results in Resected Borderline or Locally Advanced Pancreatic Adenocarcinoma? An AGEO-FRENCH Multicentric Cohort. Ann Surg Oncol. janv 2019;26(1):109-17.
- Tzeng CWD, Balachandran A, Ahmad M, Lee JE, Krishnan S, Wang H, et al. Serum carbohydrate antigen 19-9 represents a marker of response to neoadjuvant therapy in patients with borderline resectable pancreatic cancer. HPB (Oxford). mai 2014;16(5):430-8.
- Takahashi H, Yamada D, Asukai K, Wada H, Hasegawa S, Hara H, et al. Clinical implications of the serum CA19-9 level in « biological borderline resectability » and « biological downstaging » in the setting of preoperative chemoradiation therapy for pancreatic cancer. Pancreatology. juill 2020;20(5):919-28.
- Heger U, Sun H, Hinz U, Klaiber U, Tanaka M, Liu B, et al. Induction chemotherapy in pancreatic cancer: CA 19-9 may predict resectability and survival. HPB (Oxford). févr 2020;22(2):224-32.
- Liu C, Deng S, Jin K, Gong Y, Cheng H, Fan Z, et al. Lewis antigen-negative pancreatic cancer: An aggressive subgroup. Int J Oncol. avr 2020;56(4):900-8.
- Cassinotto C, Cortade J, Belleannée G, Lapuyade B, Terrebonne E, Vendrely V, et al. An evaluation of the accuracy of CT when determining resectability of pancreatic head adenocarcinoma after neoadjuvant treatment. European Journal of Radiology. avr 2013;82(4):589-93.
- Wagner M, Antunes C, Pietrasz D, Cassinotto C, Zappa M, Sa Cunha A, et al. CT evaluation after neoadjuvant FOLFIRINOX chemotherapy for borderline and locally advanced pancreatic adenocarcinoma. Eur Radiol. juill 2017;27(7):3104-16.
- Sadot E, Doussot A, O’Reilly EM, Lowery MA, Goodman KA, Do RKG, et al. FOLFIRINOX Induction Therapy for Stage 3 Pancreatic Adenocarcinoma. Ann Surg Oncol. oct 2015;22(11):3512-21.
- Hwang JA, Jang KM, Kim SH, Kang TW, Song KD, Cha DI, et al. Integration of different criteria for borderline resectable pancreatic cancer using classification tree analysis: the use of radiological tumour–vascular interface in correlation with surgical and pathological outcomes. Clinical Radiology. mars 2018;73(3):321.e1-321.e10.
- Panda A, Garg I, Truty MJ, Kline TL, Johnson MP, Ehman EC, et al. Borderline Resectable and Locally Advanced Pancreatic Cancer: FDG PET/MRI and CT Tumor Metrics for Assessment of Pathologic Response to Neoadjuvant Therapy and Prediction of Survival. AJR Am J Roentgenol. sept 2021;217(3):730-40.
Abréviations
AP : adénocarcinome pancréatique, ou adénocarcinome canalaire pancréatique
SG : Survie globale
SSR : Survie sans récidive SSP : survie sans progression CT : Chimiothérapie
RCT : Radio-chimiothérapie